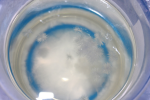

Quote
If I want to freeze this sassy I'm going to need some CaCl2 for a proper ice bath, or some dry ice.
I would imagine just plain ole NaCl on ice will bring the temp down enough for this purpose, I forget how cold it gets but definitely several degrees below zero